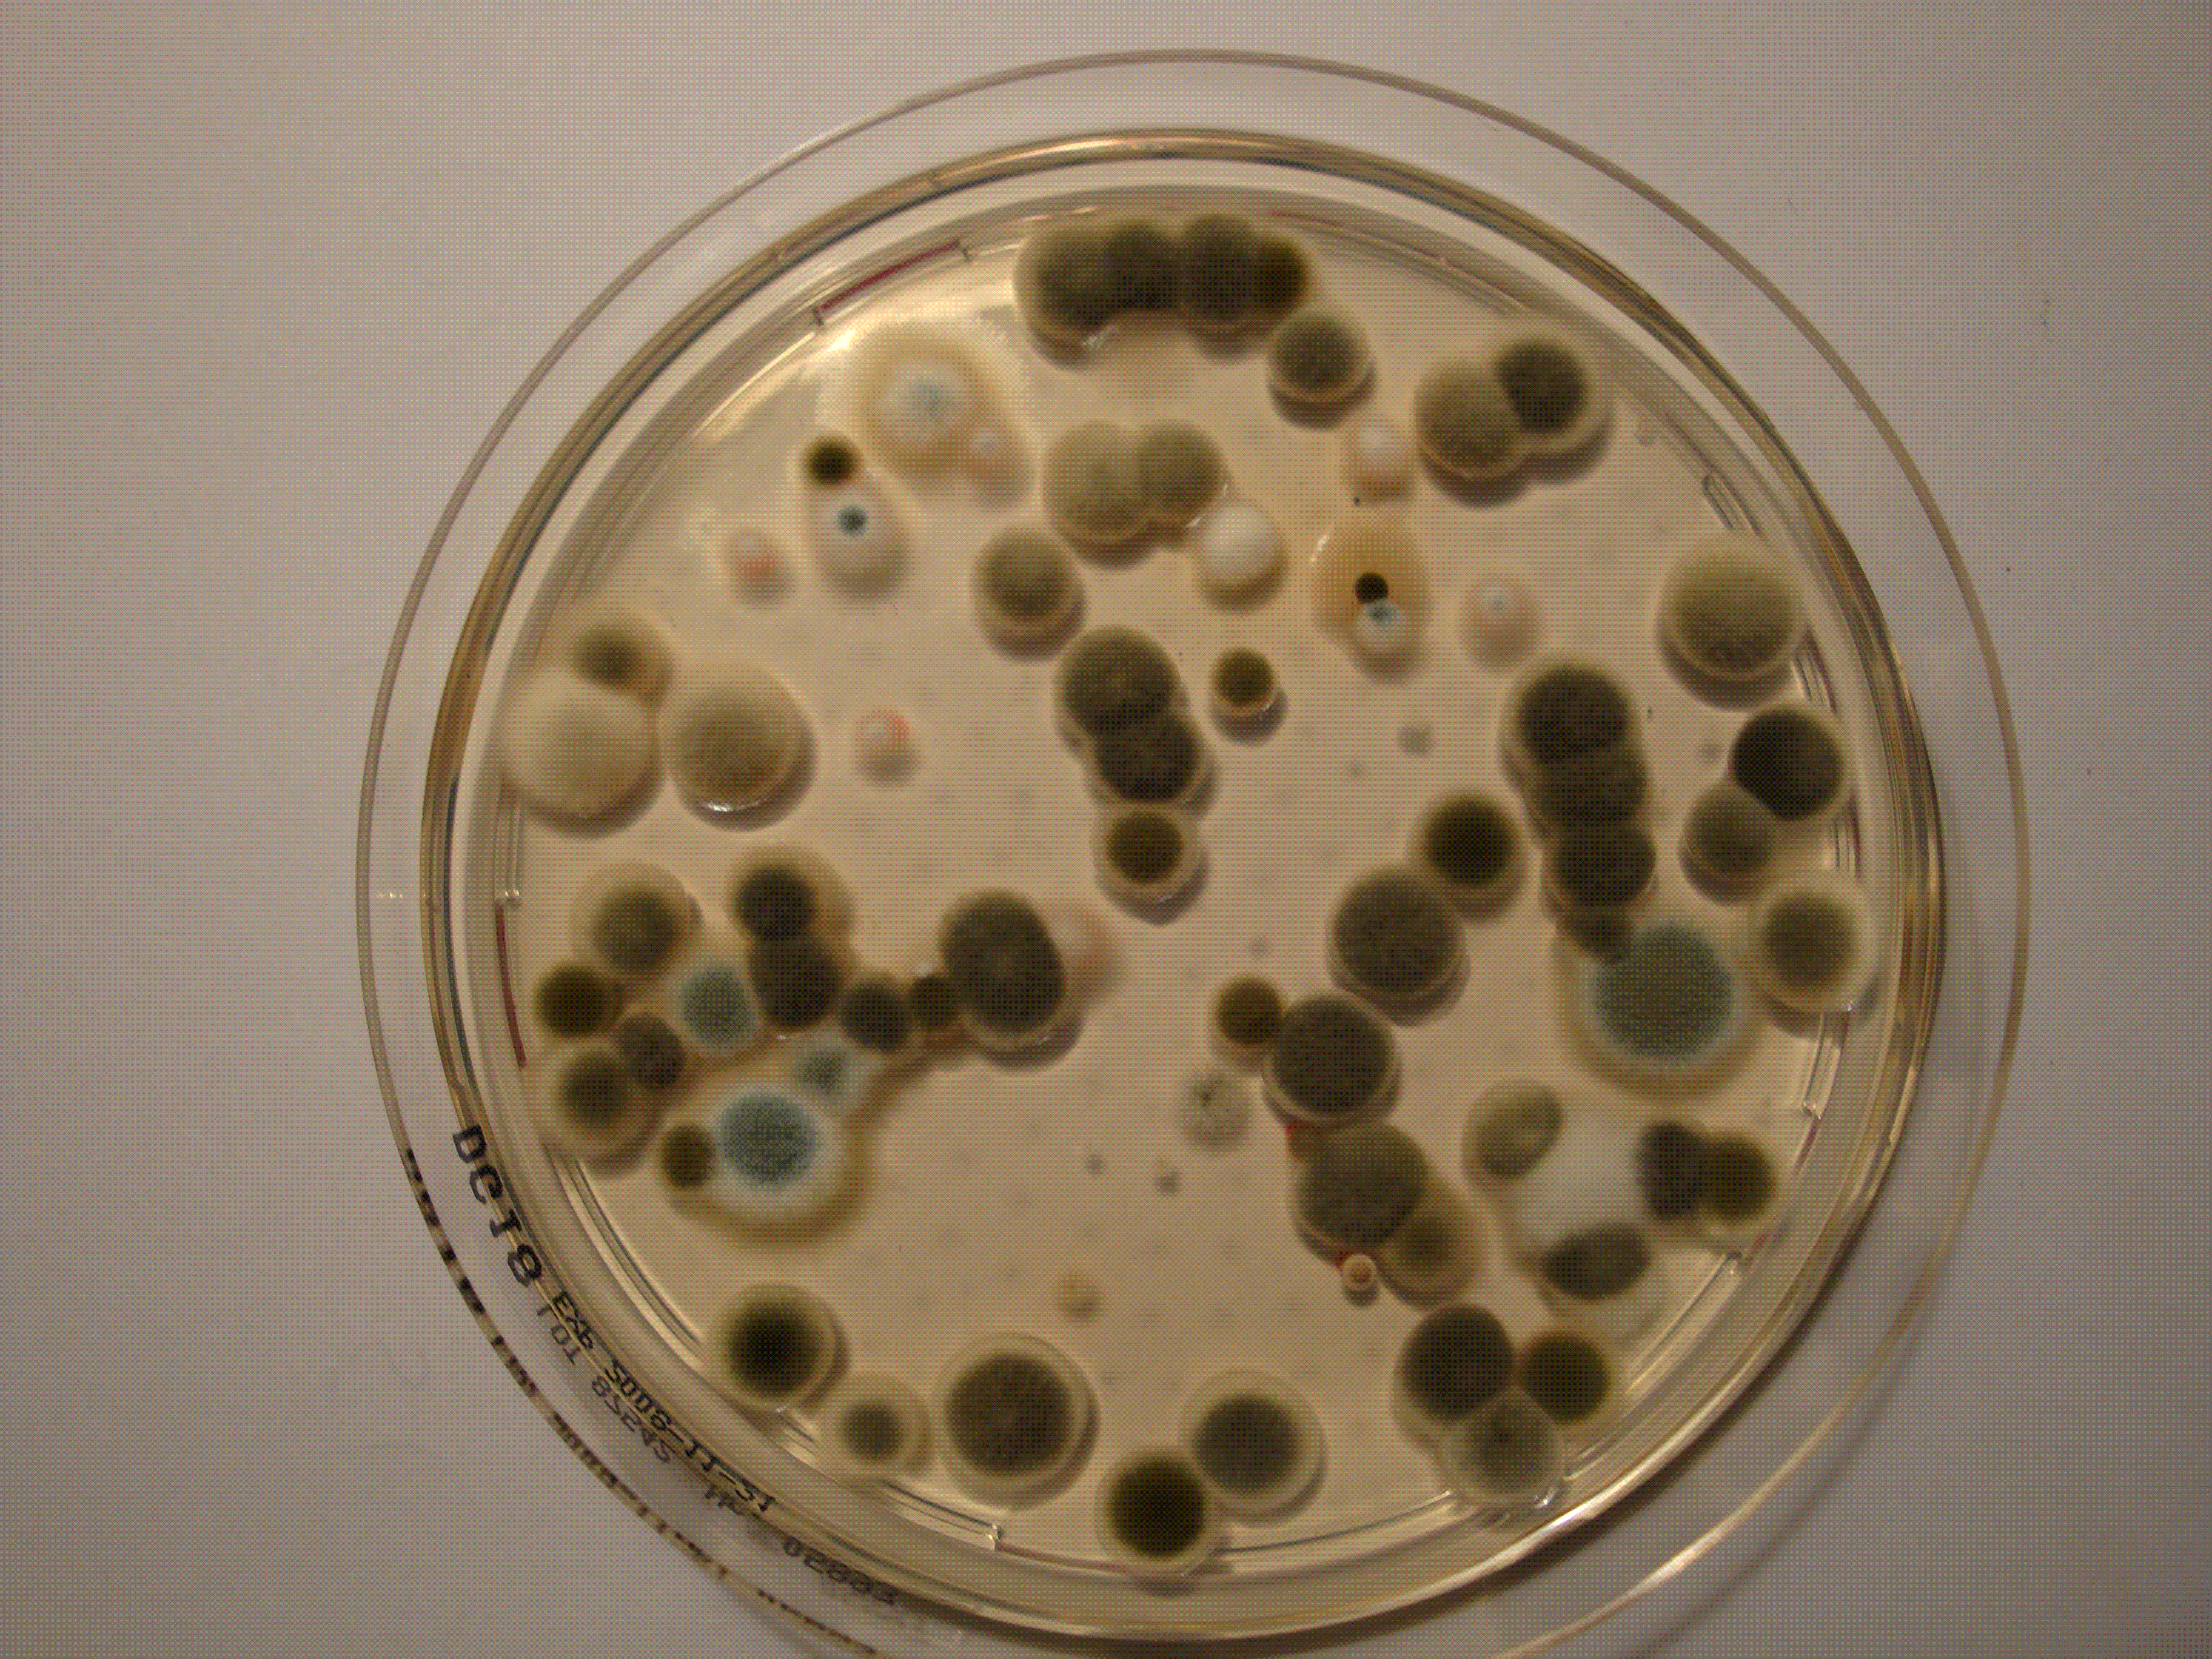

Gutachten Schimmel
Übersicht
Hier erfahren Sie wie Sie Schimmel selber beseitigen können. Eine Ursachenanalyse ist aber erforderlich, damit der Pilz auch nicht wiederkehrt.
Ursachenanalyse
Ich identifiziere die Schimmelquellen, um effektive und nachhaltige Maßnahmen gegen Feuchtigkeitsschäden zu ermöglichen.
Umfassende Schadensbewertung
Ich bewerte die Ausprägung und Auswirkungen des Schimmels, um individuelle Sanierungskonzepte zu erstellen.
Wir entwickeln Lösungen.
Wenn Sie Schimmel zu Hause oder am Arbeitsplatz, in der KITA oder sonstwo bemerken, bereitet das naturgemäß Sorgen. Das muss nicht ein. In vielen Fällen ist das Vorkommen zwar unangenehm, aber Panik ist nicht begründet. Weil das so ist, können Sie oft Schimmel selber beseitigen.
Aber: Was ist die Ursache für den Schimmel? Die schädlichen Pilze gedeihen nur, wenn geügend Feuchtigkeit und Nahrung vorhanden sind. Das ist nicht immer ganz klar und hier kann ich Ihnen helfen. So sparen Sie Geld, wenn Sie den Schimmel selbst entfernen, können aber aufgrund meiner Untersuchungen und Lösungsvorschläge sicher sein, dass die Lösung von Dauer ist.

Noch ein Wort zu meiner Arbeit. Häufig ensteht Streit zwischen Mietern und Vermietern, wer für den Schaden verantwortlich ist (wer das Ganze bezahlen soll). Ich bin davon überzeugt, dass es viel wichtiger ist, die Ursache zu finden, als einen „Schuldigen“ festzustellen. Streit bedeuten unter Umständen Kosten für Anwälte und Gerichte. Die Nerven werden strapaziert und ich deshalb biete an, zu vermitteln.
Mirkoskopische Analyse

Mycometer – Verfahren

Gebäudeanalyse

Kontaktieren Sie uns.
Lassen Sie sich beraten und erhalten Sie nachhaltige Lösungsvorschläge gegen Schimmel.
